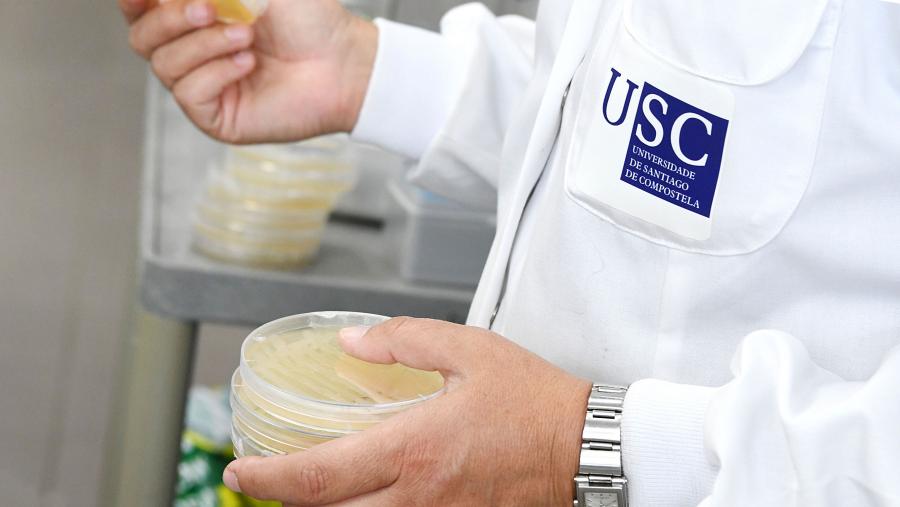
Este foro, coordinado polo investigador da USC David Serantes e por Roy Chantrell, profesor da University of York no Reino Unido, contará con 70 participantes procedentes dunha vintena de institucións internacionais. Imaxe de arquivo dun laboratorio da USC. FOTO: Santi Alvite

Un foro profunda na hipertermia con nanopartículas magnéticas como tratamento contra o cancro
A hipertermia con nanopartículas magnéticas é un tratamento que toma como punto de partida o feito de que as células tumorais sexan máis sensibles aos incrementos de temperatura que as sas. Dado que os imáns poden quentarse baixo a acción de campos magnéticos, esta técnica consiste en situar nanopartículas magnéticas (nanoimáns) no tumor, para activalos de xeito remoto e así crear un aumento local de temperatura, provocando directamente a apoptose celular (morte controlada), ou volvendo as células máis sensibles a outros tratamentos. Coa vontade de profundar nesta técnica, a Facultade de Física e o Instituto de Materiais da USC (iMATUS) organizan na Facultade de Óptica e Optometría o ‘3rd Workshop on Magnetic Nanoparticles and Hyperthermia’ que se desenvolverá entre os días 19 e 21 de abril.
Este foro, coordinado polo investigador da USC David Serantes e por Roy Chantrell, profesor da University of York no Reino Unido, contará con 70 participantes procedentes dunha vintena de institucións internacionais e 13 do conxunto do Estado. “Nesta xuntanza búscase debater con especialistas aspectos concretos que consideramos necesitan resolverse para permitir maiores avances”, explica o profesor Serantes. A xuntanza terá fundamentalmente un enfoque de ciencia de materiais.
“A vantaxe desta técnica é o feito de que o corpo humano é esencialmente insensible a campos magnéticos, e que hai nanoimáns moi biocompatibles, o que permitiría a súa aplicación médica”, engade David Serantes. O tratamento do cancro de glioblastoma por hipertermia recibiu a aprobación médica na UE xa hai máis dunha década; o de páncreas atópase aínda en fase de estudo clínico, “cuns primeiros pacientes tratados en Barcelona o ano pasado, no contexto dun proxecto europeo”, matiza. Malia que a aplicación levantou moitas expectativas, “o certo é que non acadou o éxito esperado, non pertencendo aínda á práctica clínica habitual”, sinala.